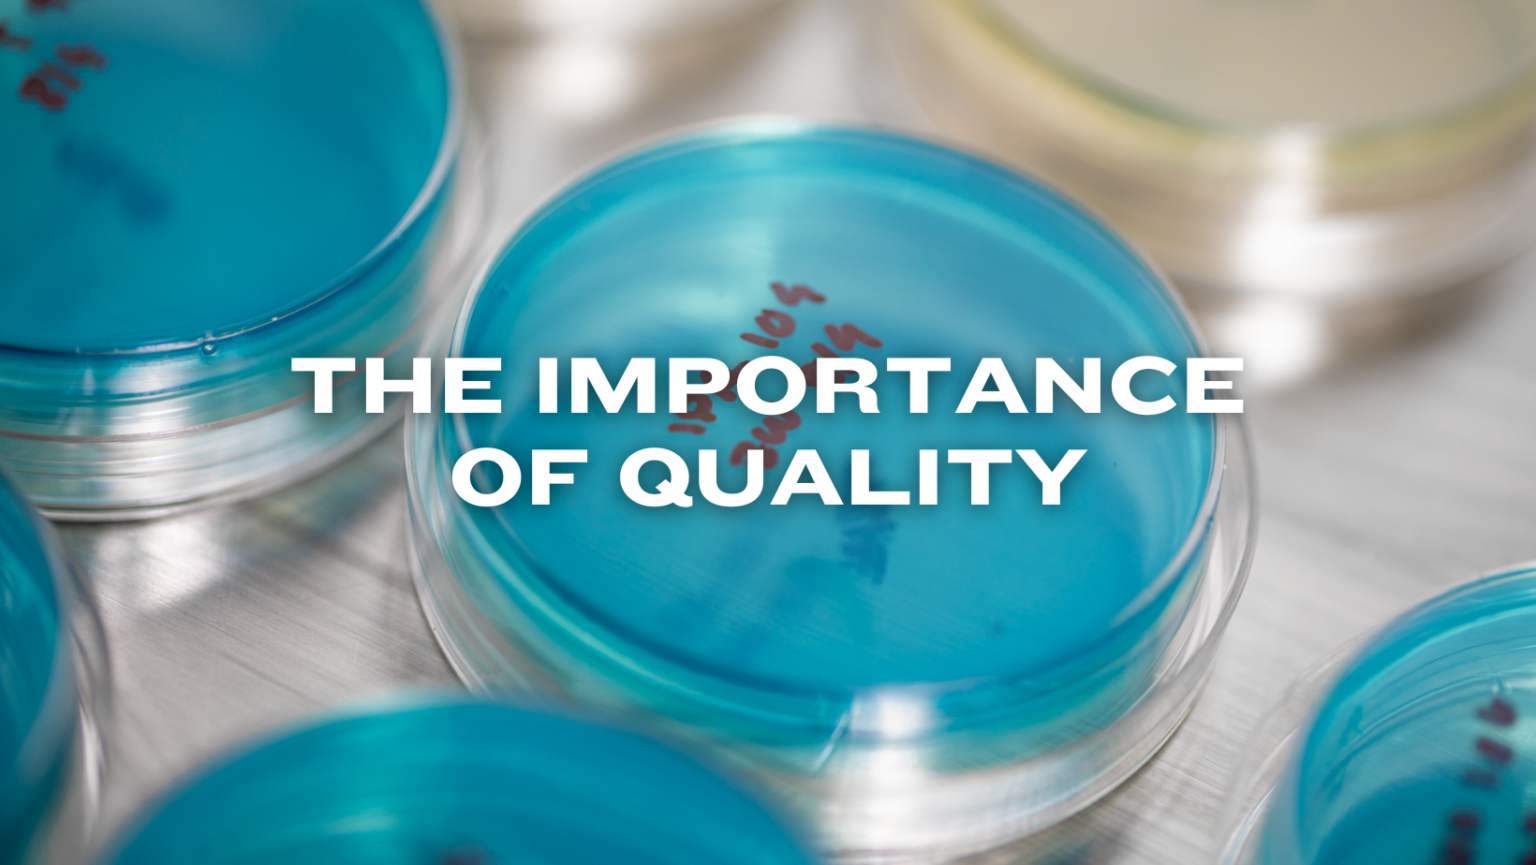
The Importance of Quality

The Importance of Quality
I began my career a decade ago as a production quality control scientist for a biotech company and, in 2022, decided to merge my passions for chemistry and beer by joining the brewing industry. While I first learned the brewing process on a 10-barrel brewhouse at Battery Steele Brewing Company, I next sought to work at Baxter because I was attracted to Baxter’s commitment to quality beer, monitored by a robust Quality Control (QC) program. Specifically, I wanted to join a team that values quality as much as I do and that makes sure each batch of beer is as consistent as possible. After joining the team, I quickly learned that Baxter’s QC program goes beyond maintaining standards. Our QC approach embodies the essence of the brew and ensures that each can reflects Baxter’s commitment to excellence. For example, sensory analysis is the frontline of quality control because it engages the human senses to detect nuances in flavor, aroma, and appearance that machines may overlook. It’s an art form that engages trained panelists to discern the subtleties that define a brand’s signature brews. Every employee at Baxter has the opportunity to participate in our sensory program panels and to determine the “True-to-target” characteristics that are set for each beer.
Our QC program also engages in shelf-life testing, which means predicting how a beer will age over time. This is another critical component of quality control because it not only guarantees that the consumer enjoys the beer as intended, it also safeguards the brewery’s reputation. Likewise, Alcohol by Volume (ABV) testing ensures legal compliance and consumer trust, as accurate labeling is not just a regulatory requirement, but a promise to the customer. At Baxter, we also complete dissolved carbon dioxide and oxygen level testing as well as microbiological testing. The first two are crucial because carbon dioxide gives beer its lively effervescence while oxygen, if not managed properly, can lead to premature aging and off-flavors, which compromises the integrity of the beer. Microbiological testing monitors for unwanted organisms that could spoil a batch, ensuring the safety and longevity of the product.
The scope of our QC Program extends beyond these tests. Monitoring and managing raw ingredients is equally important since they are the heart and soul of a beer’s flavor, aroma, color, and clarity. Specifically, yeast is the primary organism responsible for converting sugars into alcohol and carbon dioxide during fermentation. The health and vitality of the yeast strain directly impact the final product and any brewery must carefully select and manage yeast strains to achieve desired flavors and characteristics. This includes proper storage, propagation, and pitching techniques. Since yeast plays a vital role in the brewing process and can impact the final product, our yeast management is one of the most critical aspects of our QC program here at Baxter.
All in all, the implementation and management of a QC program is indispensable for breweries and Baxter’s comprehensive QC program exceeds the industry standard for breweries of its size. Here at Baxter, our dedication to high-quality beer that has been rigorously tested and refined not only guarantees the consistency and safety of our beer but also enhances the consumer’s experience and fosters trust in our brand. In an industry where passion and precision go hand in hand, quality control is the invisible architect of well-loved beers and highly regarded breweries.
–Bram, Lab Technician
![]()

